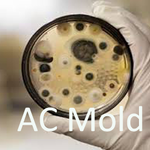

Serving Burton, MI and surrounding areas
Approved
In business since 2010
Emergency services offered
Warranties offered
"Reasonably priced, very friendly, and very knowledgeable! Really happy with my experience. "








Serving Burton, MI and surrounding areas
Approved
In business since 2010
Emergency services offered
Warranties offered
"Reasonably priced, very friendly, and very knowledgeable! Really happy with my experience. "

Serving Burton, MI and surrounding areas
Approved
In business since 2008
Emergency services offered
Small jobs welcome
"Prompt, thorough, knowledgeable, affordable."





+68

Serving Burton, MI and surrounding areas
Approved
In business since 2019
Free estimates
Emergency services offered
"I had a home inspection done by Gilbert from Varela Renovations for a house I’m trying to buy. He did a very thorough job and took his time checking everything. He explained things in a way I could easily understand, which helped me feel confident about the home. Gilbert also made sure to tell me if anything he found could be a problem for the FHA appraisal, which was very helpful. I could tell he really cared and wasn’t just rushing through the inspection. I would 110% call Gilbert again for another inspection or for any work I need done. I highly recommend him!"





+41

Serving Burton, MI and surrounding areas
Approved
In business since 2013
Free estimates
Customers say: Quick response
"We are very happy wit the whole process."





+3

Serving Burton, MI and surrounding areas




From average costs to expert advice, get all the answers you need to get your job done.

Budget for mold remediation costs based on factors such as severity, location in the home, type of mold, damage type, and more.

Budget for mold inspection costs based on factors such as the size of your home, testing type, mold type, location, accessibility, and more.

Curious who installs radon mitigation systems? Learn who to hire, why specialists matter, and what radon mitigation costs so you can take safe action now.

Not sure who to call for mold removal? See when to hire a mold specialist or restoration pro, plus costs and steps to expect.

Curious who to call for a mold inspection? Discover mold inspection costs, pro options, and what to expect before you book.

Find who to call to test water for lead. Learn when to hire a certified water testing professional or state-certified laboratory and what to expect.